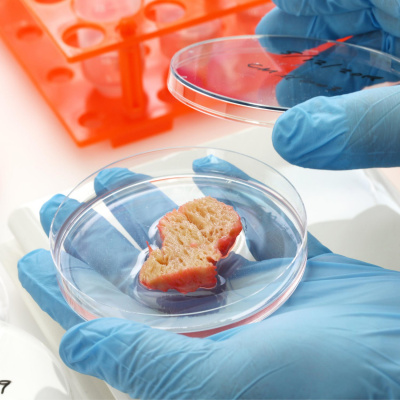
Highlights From Lunchtime Live

Highlights From Lunchtime Live
'I wouldn't call it meat!': Would you eat lab grown meat products?
- Autor: Vários
- Narrador: Vários
- Editor: Podcast
- Duración: 0:11:11
- Mas informaciones
Informações:
Sinopsis
Would you eat meat that was grown in a lab? The Unites States has become the second country to go ahead to make lab grown meat commercially available. They have granted approvals to two companies to sell chicken grown directly from animal cells in a lab. Singapore gave lab grown chicken the green light back in 2020. Is it the way of the future? Andrea was joined by listeners to discuss...